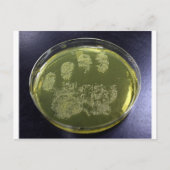
Hand Petri Dish Bacteria Briefkaart (Voorkant)

Over Briefkaarten
Aangeboden door
Over dit ontwerp
Hand Petri Dish Bacteria Briefkaart
Een foto van Staphylococcus aureus die groeit op een mannitolzout agar bord.
Ontwerp van international designer
Klant beoordelingen
4.5 van 5 sterren beoordeling28 aantal beoordelingen
28 Reviews
Beoordelingen voor identieke producten
3 van 5 sterren beoordeling
Door Anoniem13 juli 2024 • Geverifieerde aankoop
Briefkaart, Maat: Standaard Briefkaart, Papier: Signature Mat, Enveloppen: Geen
It's a nice picture, however it doesn't touch the edges of the card. Plus, the cut after print is done poorly. It's printed nicely, but the finish isn't good
5 van 5 sterren beoordeling
Door M.18 mei 2022 • Geverifieerde aankoop
Briefkaart, Maat: Standaard Briefkaart, Papier: Signature Mat, Enveloppen: Geen
Zazzler recensent programma
It is beautiful! Now I want to visit this museum. Perfect. Love the texture of the paper.
4 van 5 sterren beoordeling
Door Anoniem13 juli 2024 • Geverifieerde aankoop
Briefkaart, Maat: Standaard Briefkaart, Papier: Signature Mat, Enveloppen: Geen
Again, edges poorly cut. Print OK, badly cut edges
Tags
Andere Info
Product ID: 239851273002177006
Ontworpen op: 24-12-2013 9:11
Rating: G
Recent bekeken items